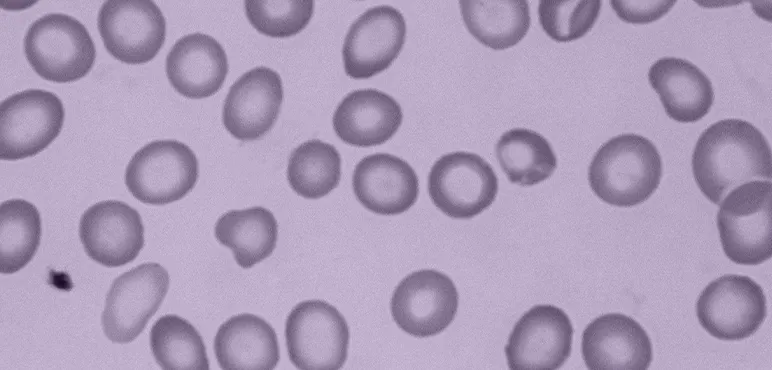
Iron deficiency anemia shown in red blood cells at 400X. Due to lesser amounts of haemoglobin, the cells have an abnormally large central pallor

Historically, the World Health Organisation defined malnutrition as a lack of caloric or protein intake. Its impact was apparent and devastating, with infants and children not having enough food to eat, leading to stunting and wasting, and even death from extreme hunger. With about 17% of the world population being underweight and 45% of deaths among children under five being linked to malnutrition, this is still a problem in some parts of the world. Today, we also face a new, less visible form of malnutrition, ‘hidden hunger’ - enough calories but too few micronutrients.

Some still define malnutrition as undernutrition, but it also includes overnutrition, leading to overweight and obesity, often in combination with an inadequate intake of vitamins or minerals.1 This combination of overnutrition and undernutrition is called ‘the double burden of malnutrition’. Likewise, hidden hunger is not only seen in low-resource countries but is a global trend following the rise of extreme shifts in diets worldwide. An estimated 2 billion people worldwide suffer from a chronic deficiency of micronutrients, with far-stretching consequences.2 To understand how hidden hunger can impact us all, let’s take a closer look at the most prevalent form of micronutrient malnutrition: iron deficiency.
The impact of iron deficiency
Mild iron deficiency impairs intellectual development in young children, while more severe cases like iron deficiency anaemia are associated with an increased risk of serious morbidity, poor motor and mental development in children, reduced work capacity in adults, poor pregnancy outcomes and impaired immune function.5,9
Today, iron deficiency anaemia is estimated to affect 1.2 billion people worldwide and remains one of the leading causes of disease burden in low- and middle-income countries.3 In 2019, the number of children under five suffering from anaemia in Africa was 60%.4 This is related to the broader issue of equity and lack of access to nutrition, as for many low-income populations, affordable foods often lack many nutrients.

A hospital worker distributes food for anaemic mothers and children at Maradi Regional Hospital. Maradi, Niger. Giles Clarke/Getty Images
Menstruating women are also more susceptible to iron deficiency anaemia as they lose iron through menstrual blood loss, and there may not be enough iron in their diet to balance this blood loss. Young children, during periods of rapid growth, are also susceptible to iron deficiency anaemia if they are not exposed to iron-rich foods in early life. This is particularly the case for children born to iron-deficient mothers.
A cause for global concern
Iron deficiency anaemia is not a problem confined to the low-income regions. High rates of iron deficiency and iron deficiency anaemia are still prevalent in resource-secure countries and are often overlooked. Worldwide, one-third of women and 40% of children under five suffer from anaemia.10 With a rise in processed food consumption, modern diets often lack the nutrients our bodies require. In the UK, for example, about 70% of our diets are made up of processed or ultra-processed foods.11
Diets that are thought to be ‘healthy’ - if improperly considered - may also lack adequate nutrition. For instance, with the growing popularity of exclusively plant-based diets, some key nutrients may be overlooked - particularly nutrients that are more bioavailable in animal products, like iron. The most iron-rich foods are animal-based protein (e.g. liver, red meat, sardines, oysters, mussels and clams), while our body’s absorption of iron is lower from plant-based sources. Of course, adequate iron nutrition can be secured through plant-based sources. However, plant-based eaters must take care to diversify their diet with nutritious iron sources such as dark leafy greens, dark orange veg (such as carrots and sweet potatoes), bread (especially sourdough), beans and pulses. Iron from plant sources that is ingested together with vitamin C rich foods (such as peppers and strawberries), is also better absorbed by the body. Unfortunately, other dietary choices can inhibit iron absorption. For example, meals taken in combination with coffee, black tea or alcohol will reduce iron absorption.
Holistic view of nutrition
So, while many populations may be at less risk of undernutrition today, hidden hunger is increasingly present. Unfortunately, this does not simply come down to good and bad food choices. It’s vital to not only look at nutrition through a singular lens. To improve nutrition status, we must look at our overall diet and lifestyle choices. Are we getting enough sleep, drinking enough water and eating a varied diet? Are we eating foods, such as probiotics like fermented foods (yoghurt, sourdough, kimchi), that benefit our gut microbiome? This is also important for the absorption of some important nutrients. However, this also ties into the ethics of access to food, where in resource-poor settings, these foods or lifestyle choices are often not accessible.
Iron deficiency anemia shown in red blood cells at 400X. Due to lesser amounts of haemoglobin, the cells have an abnormally large 'central pallor' (transparent centre).
Innovations against iron malnutrition
These modern forms of malnutrition are a threat to our global public health and future prosperity. Luckily, there are exciting initiatives against iron malnutrition that are beneficial to both low-income and resource-secure regions.
Iron Supplementation
Older forms of iron supplements were not well-absorbed by the body (less than 10-20% absorption), with the majority of the iron passing through the intestine unabsorbed, where it can cause some side effects such as constipation or diarrhoea. Constipation can decrease food intake and diarrhoea can exacerbate nutrient loss, both contributing to higher levels of malnourishment. New forms of iron supplementation are more readily absorbed or better tolerated by the body and are being developed and tested in clinical and field settings. IHAT (Iron Hydroxide Adipate Tartrate), for example, attempts to mimic natural food iron found in plant and animal sources.12 There are novel forms of iron application, like intravenous iron*, for the more severe cases of iron deficiency anaemia.
Iron Fortification
Scientists are also developing novel home and food fortification strategies, specifically targeting low-resource regions. These include using multi-micronutrient powders and single-dose packets of vitamins and minerals in powder form that can be sprinkled onto any ready-to-eat food. These powders readily increase the micronutrient content of a child's diet without changing their usual dietary habits. Prebiotic compounds have recently been shown to be useful when added to iron formulations to increase absorption of fortificant iron and alleviate the gastrointestinal side-effects of unabsorbed iron in the gut.13
Biofortification
Biofortification is also a promising strategy. It involves fortifying staple crops by selecting varieties with an increased content of particular micronutrients, such as vitamin A in golden rice. This new technology involves using agronomic practices to increase nutrient levels of crops during plant growth. For example, HarvestPlus is developing new, more nutritious varieties of staple food crops with higher amounts of vitamin A, iron, or zinc. Biofortification may offer alternatives for populations where supplementation and traditional fortification are limited.
The driving forces behind malnutrition are many and nuanced. The consequences are not only immediate but also impact the prosperity of future generations with hidden hunger and the double burden of malnutrition inhibiting adequate development. There needs to be a shift in our dietary focus on adding more variety (legumes, nuts, seeds, grain, fruits, vegetables and nutrient-rich animal-sourced foods) to alleviate micronutrient deficiencies. Variety is also crucial because while iron is one form of micronutrient malnutrition and often a cause of hidden hunger, many other nutrients are lacking in populations today, such as vitamin A and iodine. Together with healthier diets, many exciting modern innovations help tackle traditional malnutrition, hidden hunger and the double burden of malnutrition.



